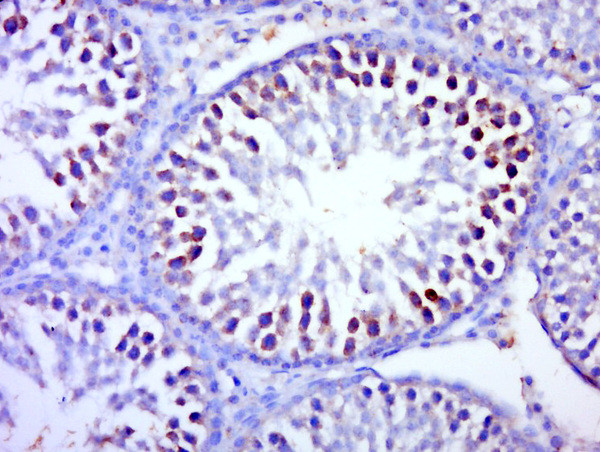
BTBD1 Antibody in Immunohistochemistry (Paraffin) (IHC (P))

Search
Bioss
BTBD1 Polyclonal Antibody
{{$productOrderCtrl.translations['antibody.pdp.commerceCard.promotion.promotions']}}
{{$productOrderCtrl.translations['antibody.pdp.commerceCard.promotion.viewpromo']}}
{{$productOrderCtrl.translations['antibody.pdp.commerceCard.promotion.promocode']}}: {{promo.promoCode}} {{promo.promoTitle}} {{promo.promoDescription}}. {{$productOrderCtrl.translations['antibody.pdp.commerceCard.promotion.learnmore']}}
图: 1 / 2
BTBD1 Antibody (BS-9294R) in IHC (P)


产品信息
BS-9294R
种属反应
宿主/亚型
分类
类型
抗原
偶联物
形式
浓度
规格
纯化类型
保存液
内含物
保存条件
运输条件
靶标信息
The C-terminus of BTBD1 binds topoisomerase I. The N-terminus contains a proline-rich region and a BTB/POZ domain (broad-complex, Tramtrack and bric a brac/Pox virus and Zinc finger), both of which are typically involved in protein-protein interactions. Subcellularly, the protein localizes to cytoplasmic bodies. The C-terminus of the protein encoded by this gene binds topoisomerase I. The N-terminus contains a proline-rich region and a BTB/POZ domain (broad-complex, Tramtrack and bric a brac/Pox virus and Zinc finger), both of which are typically involved in protein-protein interactions. Subcellularly, the protein localizes to cytoplasmic bodies. Alternative splicing results in multiple transcript variants encoding different isoforms.
仅用于科研。不用于诊断过程。未经明确授权不得转售。
篇参考文献 (0)
生物信息学
蛋白别名: BTB (POZ) domain containing 1; BTB-containing Kelch-like protein; BTB/POZ domain-containing protein 1; C15orf4; Glucose signal-repressing protein; HCV NS5A-transactivated protein 8; Hepatitis C virus NS5A-transactivated protein 8; POZ; unnamed protein product
基因别名: 1190005H08Rik; BTBD1; C15orf1; Gsrp; NS5ATP8
UniProt ID: (Human) Q9H0C5, (Mouse) P58544
Entrez Gene ID: (Human) 53339, (Mouse) 83962, (Rat) 293060